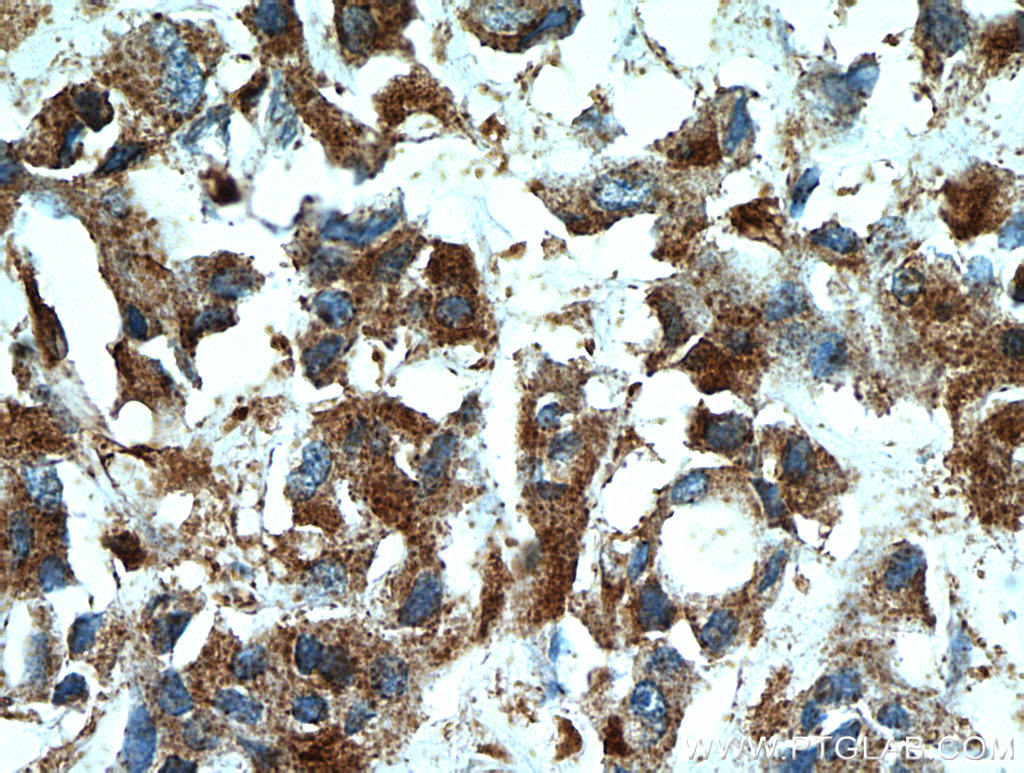

验证数据展示
经过测试的应用
| Positive IHC detected in | rat brain tissue, mouse brain tissue, human breast cancer tissue Note: suggested antigen retrieval with TE buffer pH 9.0; (*) Alternatively, antigen retrieval may be performed with citrate buffer pH 6.0 |
推荐稀释比
| 应用 | 推荐稀释比 |
|---|---|
| Immunohistochemistry (IHC) | IHC : 1:50-1:500 |
| It is recommended that this reagent should be titrated in each testing system to obtain optimal results. | |
| Sample-dependent, Check data in validation data gallery. | |
产品信息
55009-1-AP targets WDFY3/ALFY in WB, IHC, IF, ELISA applications and shows reactivity with human, mouse, rat samples.
| 经测试应用 | IHC, ELISA Application Description |
| 文献引用应用 | WB, IHC, IF |
| 经测试反应性 | human, mouse, rat |
| 文献引用反应性 | mouse |
| 免疫原 |
Peptide 种属同源性预测 |
| 宿主/亚型 | Rabbit / IgG |
| 抗体类别 | Polyclonal |
| 产品类型 | Antibody |
| 全称 | WD repeat and FYVE domain containing 3 |
| 别名 | WDFY3, WDFY3 / ALFY, Alfy, Autophagy linked FYVE protein, Autophagy-linked FYVE protein |
| 计算分子量 | 395 kDa |
| GenBank蛋白编号 | NM_014991 |
| 基因名称 | WDFY3 |
| Gene ID (NCBI) | 23001 |
| RRID | AB_10863126 |
| 偶联类型 | Unconjugated |
| 形式 | Liquid |
| 纯化方式 | Antigen affinity purification |
| UNIPROT ID | Q8IZQ1 |
| 储存缓冲液 | PBS with 0.02% sodium azide and 50% glycerol, pH 7.3. |
| 储存条件 | Store at -20°C. Stable for one year after shipment. Aliquoting is unnecessary for -20oC storage. |
背景介绍
WDFY3, also named as KIAA0993 and Alfy, is a protein which contains WD repeats and an FYVE domain. Multiple alternatively spliced transcript variants have been found for WDFY3, but the full-length nature of some variants has not been defined. The antibody is specific to WDFY3.The band 50kd in WB is a splicing form of WDFY3.
实验方案
| Product Specific Protocols | |
|---|---|
| IHC protocol for WDFY3/ALFY antibody 55009-1-AP | Download protocol |
| Standard Protocols | |
|---|---|
| Click here to view our Standard Protocols |
发表文章
| Species | Application | Title |
|---|---|---|
Cardiovasc Res WD40 repeat and FYVE domain containing 3 (Wdfy3) is essential for cardiac development.
| ||
In Vitro Cell Dev Biol Anim Autophagy-linked FYVE protein (Alfy) promotes autophagic removal of misfolded proteins involved in amyotrophic lateral sclerosis (ALS). | ||
Mol Cell Proteomics Spinal cord phosphoproteome of SCA2 mouse model reveals alteration of ATXN2-N-term PRM-SH3-actin interactome and of autophagy | ||
Res Sq Genetic depletion of early autophagy protein ATG13 impairs mitochondrial energy metabolism, augments oxidative stress, induces the polarization of macrophages to M1 inflammatory mode, and compromises myelin integrity in skeletal muscle. | ||
Inflamm Res Genetic depletion of the early autophagy protein ATG13 impairs mitochondrial energy metabolism, augments oxidative stress, induces the polarization of macrophages to the M1 inflammatory mode, and compromises myelin integrity in skeletal muscle. |